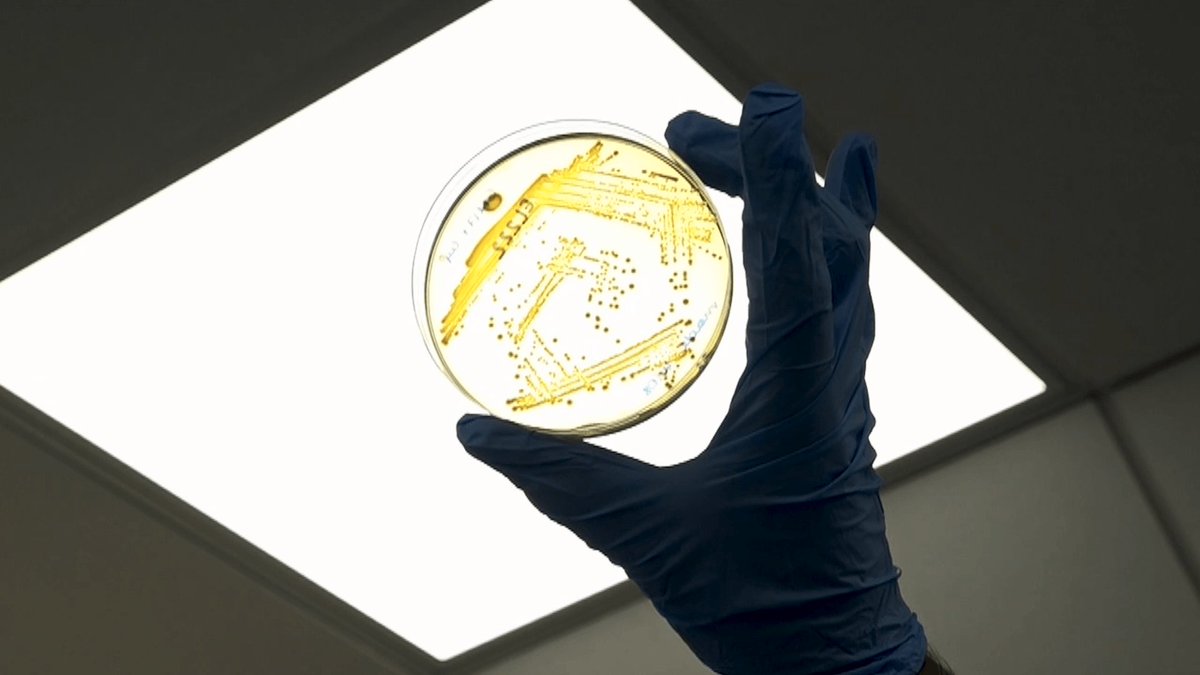
AdvPortfolio's tweet image. Transforming human stem cells into bone with the help of non-pathogenic bacteria  @UofGlasgow #stemcells #RegenMed #healthcare #materials #bones - Watch how it's done: ow.ly/Iedl30mFj3S

#boneengineering resultados de búsqueda
Bone is a strong yet lightweight structure with astonishing self-repair capabilities, but when the bone can't heal, science comes to the rescue. Read our new highlight on a new approach for bone tissue engineering Click here: bit.ly/3GfOES1 #BoneEngineering #chitosan

Where you are, I don't know but very sure of getting you #PhDposition #bone #boneengineering #tissueengineering #BME #PhD
Tissue culture models of muscle implants benefit from the fascia layer by the improved delivery of BMP-2. This could help to optimize the osteo-regenerative tissue grafts & contribute to the development of gene-enhanced #boneengineering technologies. ow.ly/4sA330nWacV
I know these people! Very cool work coming out of the Division of Biomedical Engineering at @UofGlasgow. #stemcells #boneengineering #advancedmaterials
Transforming human stem cells into bone with the help of non-pathogenic bacteria @UofGlasgow #stemcells #RegenMed #healthcare #materials #bones - Watch how it's done: ow.ly/Iedl30mFj3S

In their latest publication Hai Xin & team discuss development of an ex vivo #perfusion bioreactor system to maintain the cellular #viability and metabolism of surgically resected periosteal flaps. Read here: buff.ly/44fwD1u #boneengineering #transplantation #bonerepair
3D-printed PCL-gelatin scaffolds with nanohydroxyapatite and nanoclay show enhanced porosity, strength, and bioactivity for bone regeneration. #BoneEngineering #3DPrinting rimpacts.com/rd/p?c=1013421…
rimpacts.com
Fabrication and Characterization of 3D Nanostructured Polycaprolactone-Gelatin/Nanohydroxyapatite...
3D-printed PCL-gelatin scaffolds with nanohydroxyapatite and nanoclay show enhanced porosity, strength, and bioactivity for bone regeneration. #BoneEngineering #3DPrinting
Read the latest in #boneengineering research. Per @ColumbiaBME @ColumbiaGenDev Prof. Gerard Karsenty, “#Osteocalcin seems to be able to reverse manifestations of ageing in the #brain and in #muscle.” #tissueengineering #boneresearch @ColumbiaMed @CUSEAS bit.ly/3gzFYIv
Hey #boneengineering and #biomedical engineering people. I need textbooks covering bone growth, chemical makeup, structure and design. Any suggestions?
It's not to-marrow, it's today at 3pm! Joint us for an osteoBLAST as @BlankaSharma presents a talk on 'Regenerative Engineering for Joint Injury and Osteoarthritis'🦴 #virtualFIRM #boneengineering firmsymposium.com/register
Study shows gelatin-coated 3D-printed scaffolds enhance mechanical strength, bioactivity, and bone formation for tissue engineering. #Biomaterials #BoneEngineering rimpacts.com/rd/p?c=1013284…
rimpacts.com
Enhancing the Biological Characteristics of Aminolysis Surface-Modified 3D Printed Nanocomposite...
Study shows gelatin-coated 3D-printed scaffolds enhance mechanical strength, bioactivity, and bone formation for tissue engineering. #Biomaterials #BoneEngineering
3D-printed PCL-gelatin scaffolds with nanohydroxyapatite and nanoclay show enhanced porosity, strength, and bioactivity for bone regeneration. #BoneEngineering #3DPrinting rimpacts.com/rd/p?c=1013421…
rimpacts.com
Fabrication and Characterization of 3D Nanostructured Polycaprolactone-Gelatin/Nanohydroxyapatite...
3D-printed PCL-gelatin scaffolds with nanohydroxyapatite and nanoclay show enhanced porosity, strength, and bioactivity for bone regeneration. #BoneEngineering #3DPrinting
Study shows gelatin-coated 3D-printed scaffolds enhance mechanical strength, bioactivity, and bone formation for tissue engineering. #Biomaterials #BoneEngineering rimpacts.com/rd/p?c=1013284…
rimpacts.com
Enhancing the Biological Characteristics of Aminolysis Surface-Modified 3D Printed Nanocomposite...
Study shows gelatin-coated 3D-printed scaffolds enhance mechanical strength, bioactivity, and bone formation for tissue engineering. #Biomaterials #BoneEngineering
In their latest publication Hai Xin & team discuss development of an ex vivo #perfusion bioreactor system to maintain the cellular #viability and metabolism of surgically resected periosteal flaps. Read here: buff.ly/44fwD1u #boneengineering #transplantation #bonerepair
Hey #boneengineering and #biomedical engineering people. I need textbooks covering bone growth, chemical makeup, structure and design. Any suggestions?
Bone is a strong yet lightweight structure with astonishing self-repair capabilities, but when the bone can't heal, science comes to the rescue. Read our new highlight on a new approach for bone tissue engineering Click here: bit.ly/3GfOES1 #BoneEngineering #chitosan

Where you are, I don't know but very sure of getting you #PhDposition #bone #boneengineering #tissueengineering #BME #PhD
It's not to-marrow, it's today at 3pm! Joint us for an osteoBLAST as @BlankaSharma presents a talk on 'Regenerative Engineering for Joint Injury and Osteoarthritis'🦴 #virtualFIRM #boneengineering firmsymposium.com/register
Read the latest in #boneengineering research. Per @ColumbiaBME @ColumbiaGenDev Prof. Gerard Karsenty, “#Osteocalcin seems to be able to reverse manifestations of ageing in the #brain and in #muscle.” #tissueengineering #boneresearch @ColumbiaMed @CUSEAS bit.ly/3gzFYIv
Tissue culture models of muscle implants benefit from the fascia layer by the improved delivery of BMP-2. This could help to optimize the osteo-regenerative tissue grafts & contribute to the development of gene-enhanced #boneengineering technologies. ow.ly/ZtiY50mFEu5

Tissue culture models of muscle implants benefit from the fascia layer by the improved delivery of BMP-2. This could help to optimize the osteo-regenerative tissue grafts & contribute to the development of gene-enhanced #boneengineering technologies. ow.ly/gqZg50mFF3S

Tissue culture models of muscle implants benefit from the fascia layer by the improved delivery of BMP-2. This could help to optimize the osteo-regenerative tissue grafts & contribute to the development of gene-enhanced #boneengineering technologies. ow.ly/4sA330nWacV
I know these people! Very cool work coming out of the Division of Biomedical Engineering at @UofGlasgow. #stemcells #boneengineering #advancedmaterials
Transforming human stem cells into bone with the help of non-pathogenic bacteria @UofGlasgow #stemcells #RegenMed #healthcare #materials #bones - Watch how it's done: ow.ly/Iedl30mFj3S
Tissue culture models of muscle implants benefit from the fascia layer by the improved delivery of BMP-2. This could help to optimize the osteo-regenerative tissue grafts & contribute to the development of gene-enhanced #boneengineering technologies. ow.ly/ZtiY50mFEu5

Bone is a strong yet lightweight structure with astonishing self-repair capabilities, but when the bone can't heal, science comes to the rescue. Read our new highlight on a new approach for bone tissue engineering Click here: bit.ly/3GfOES1 #BoneEngineering #chitosan

Something went wrong.
Something went wrong.
United States Trends
- 1. Jupiter's Best N/A
- 2. #ENHYPEN_SEVEN_OR_NOTHING N/A
- 3. Statue of Liberty N/A
- 4. #NationalDoctorsDay N/A
- 5. Marie Harf N/A
- 6. #NO_7_NO_ENHYPEN_TOUR N/A
- 7. #MondayMotivation N/A
- 8. Wine N/A
- 9. Hurley N/A
- 10. #Supergirl N/A
- 11. Good Monday N/A
- 12. Exercise N/A
- 13. Disney World N/A
- 14. Sean McVay N/A
- 15. Holy Monday N/A
- 16. Tatsu N/A
- 17. Gears N/A
- 18. Ninjas N/A
- 19. Uzbekistán N/A
- 20. John Harbaugh N/A










